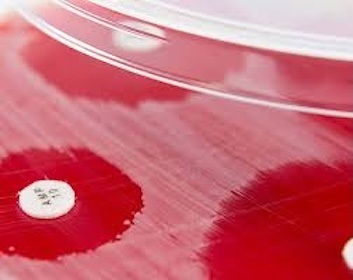
Δίσκοι ευαισθησίας αντιβιοτικών του οίκου Biomaxima

Δίσκοι Ευαισθησίας
Δισκία ελέγχου αντιμικροβιακής ή αντιμυκητισιακής ευαισθησίας του οίκου Biomaxima, κατασκευασμένα από υψηλής ποιότητας χαρτί (διάμετρος 6 mm).
Εμποτισμένα με ποσότητες αντιβιοτικού ή άλλου χημειοθεραπευτικού παράγοντα κατανεμημένες ομοιογενώς (σύμφωνα με τις διεθνείς μεθόδους και πρότυπα: EUCAST, CLSI).
Λίστα αντικειμένων
- Eυκρινώς τυπωμένοι και στις δύο πλευρές με αλφαριθμητικούς χαρακτήρες που χαρακτηρίζουν τον περιεχόμενο παράγοντα και την συγκέντρωση τους.